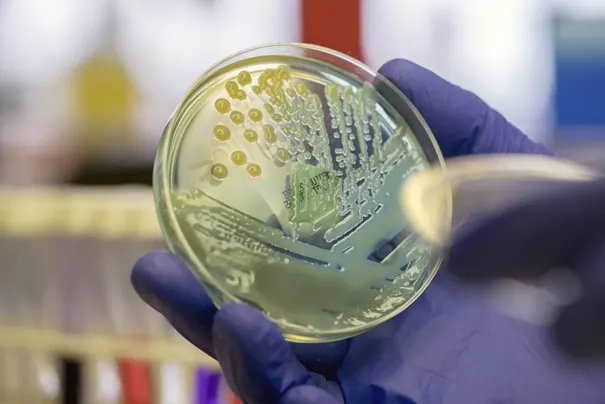

14. ágúst 2024
14. ágúst 2024
Þessi frétt er meira en árs gömul
Rannsókn hópsýkingar á Rangárvöllum
Miðvikudaginn 7. ágúst síðastliðinn barst tilkynning til Heilbrigðiseftirlits Suðurlands um að einstaklingar sem höfðu gist á Rangárvöllum í lok júlí hefðu veikst af iðrasýkingu.
Heilbrigðiseftirlit Suðurlands fór samdægurs í eftirlitsheimsókn og tók vatnssýni til rannsókna. Fyrstu niðurstöður lágu fyrir föstudaginn 9. ágúst og bentu til E. coli mengunar í vatni. Í kjölfarið fengu staðarhaldarar tilmæli um að sjóða allt neysluvatn og að upplýsa gesti um mögulega mengun. Næsta dag barst staðfesting þess að E. coli hafi greinst í vatnssýnum en þó í litlu magni. Þessar niðurstöður benda til mögulegrar mengunar í neysluvatni á svæðinu sem kallar á frekari rannsóknir og aðgerðir.
Matvælastofnun og sóttvarnalæknir voru upplýst um málið mánudaginn 12. ágúst. Þriðjudaginn 13. ágúst var boðað til fundar stýrihóps í samræmi við verklag við rannsóknir á vatns- eða matarbornum hópsýkingum. Á þeim fundi voru fulltrúar Heilbrigðiseftirlits Suðurlands, Matvælastofnunar, sóttvarnalæknis, umdæmis-/svæðislæknar Suðurlands og sýkla- og veirufræðideildar Landspítala.
Á fundinum kom fram að um nokkurn fjölda fólks virðist vera að ræða sem voru á ferðalagi á þessu landsvæði en uppruni og orsök veikindanna hafa ekki verið staðfest. Upplýsingasöfnun var skipulögð með það að markmiði að kortleggja umfang málsins, þar með talið fjölda og ferðir þeirra sem veiktust. Heilsugæslan skipuleggur sýnatökur frá einstaklingum sem tengjast málinu.
Sóttvarnalæknir